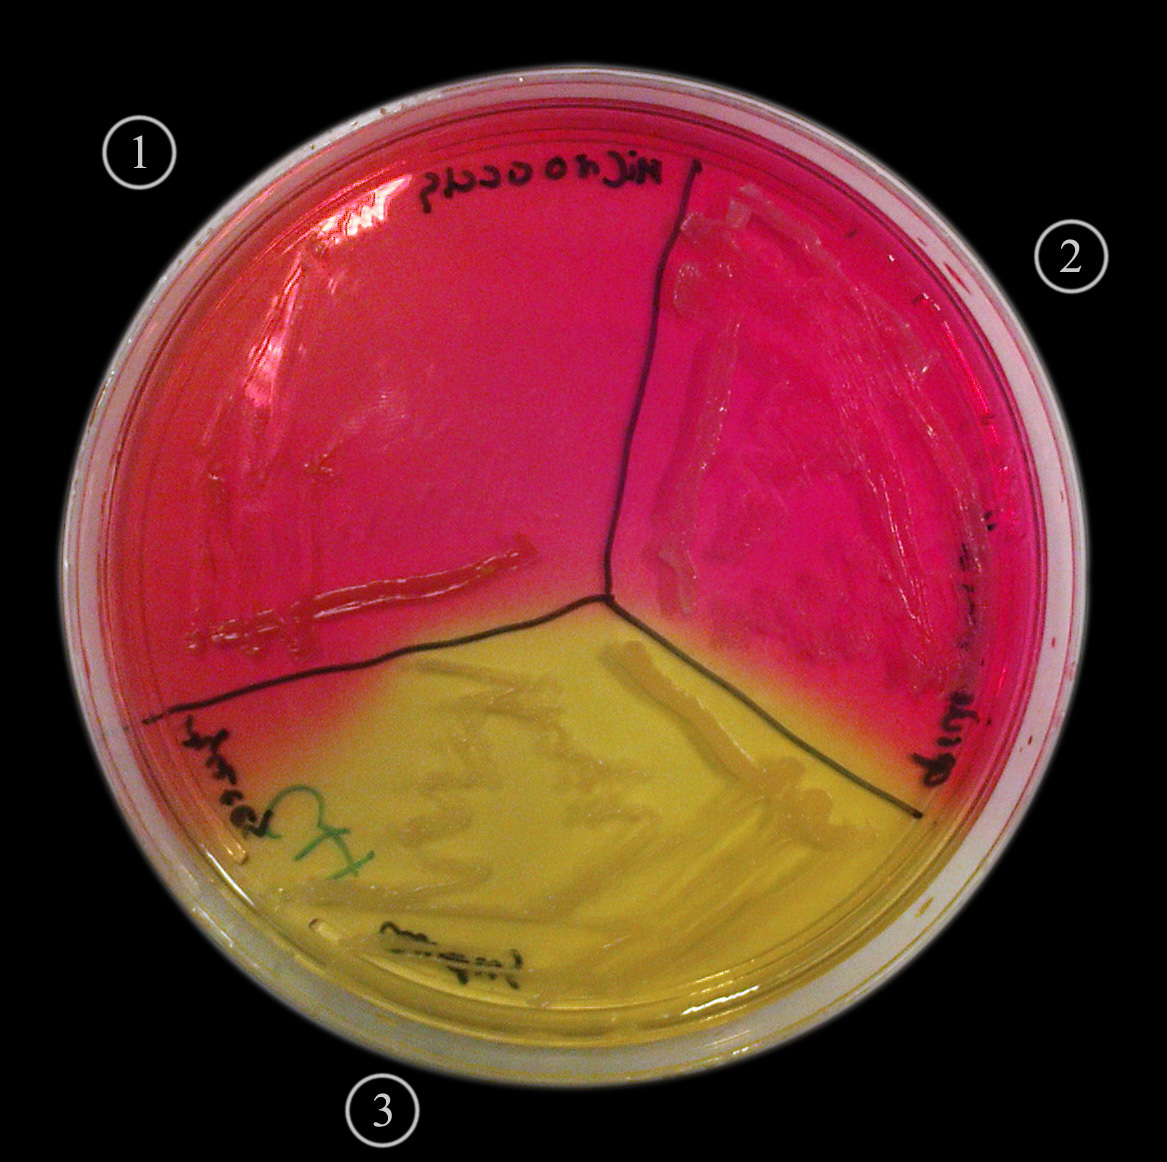
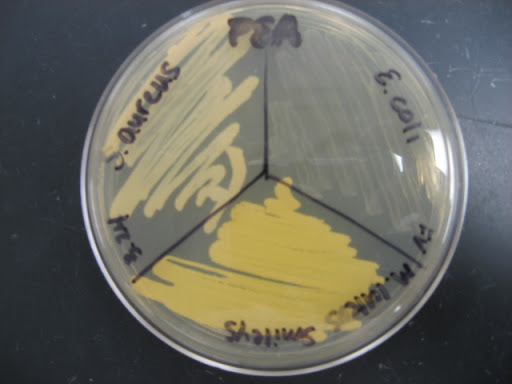
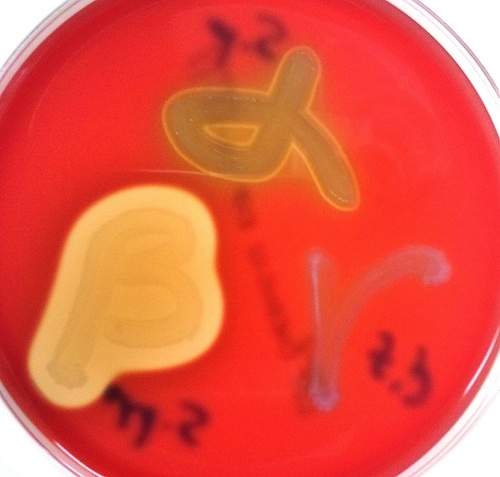
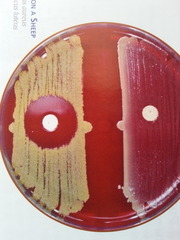

Mannitol salt agar (MSA)
- isolate Staphylococcus from mixed sample
- selective and differential
- 7% salt- only salt tolerant grow
Mannitol (sugar) is the differential agent
- survivors ferment mannitol or do not
phenol red pH indicator
Mannitol salt agar results
yellow = acidic (uses mannitol)
red= does not uses mannitol
Staphylococcus aureus- salt tolerant and uses mannitol (grows, yellow)
Staphylococcus epidermidis- salt tolerant and does not use mannitol (grows, red)
Micrococcus luteus- growth, not yellow
Streptococcus pyogenes- no growth (did not inoculate in lab)
Phenylethyl alcohol test (PEA)
selective agar isolates Gram positive species from sample containing Gram negative bacteria
-phenylethyl alcohol inhibits DNA synthesis in Gram negatives
Phenylethyl alcohol results
E. coli- negative, doesn’t grow
Staphylococcus aureus- positive, grows
Strepylococcus pyogenes- positive, grow
Staphytect Plus agglutination test
replaces the coagulase test
distinguishes Staph aureus from Staph epidermidis and other Gram positives
antibody agglutination reagent (kit) binds Staph aureus antigens (sample)
Staphytect Plus agglutiation test results
clumping and formation of blue particles- POSITIVE for Staph aureus
no clumping or blue particles- NEGATIVE for Staph aureus
Mannitol Salt Agar
yellow- uses mannitol
growth- salt tolerant
Staphyloccus aureus- salt tolerant and ferments mannitol
Staphyloccus epidermidis- salt tolerant, doesn’t use mannitol
Micrococcus luteus- salt tolerant, doesn’t use mannitol
Phenylethyl alcohol agar (PEA)
selective agar
Gram positive- grows
E. coli- negative
Staphylococcus aureus- positive
Streptococcus pyogenes- positive
Catalase test
distinguishes Staph from Streptococcus
bacteria mixed with H2O2 on slide
H2O2- catalase substrate
Product- O2(bubbles) and H2O when positive
Strep- Negative
All others- positive
Coagulase test
Coagulase hydrolyzes blood proteins
Clumping positive
Staph aureus- POSITIVE
All other bacteria NEGATIVE
Blood agar
Blood is the differential agent
Hemolysin enzymes- break down red blood cells
- Beta- clearing in blood (Staph aureus, Strep pyogenes)
- Alpha- partial clearing in blood (Strep bovis, Enterococcus)
- Gamma- Staph epidermidis
Blood agar
Beta- clearing- Staph aureus
Alpha- partial clearing- Enterococcus, Strep bovis
Gamma- no clearing- Staph epidermidis
Bacitracin Sensitivity test
“A” disc has bacitracin
Placed over bacteria on blood agar
No growth around disc- SENSITIVE- Strep pyogenes
Growth around disc- RESISTANT
Strep pyogenes- SENSITIVE
Strep pneumoniae- RESISTANT
Optochin sensitivity
“P” disc
Streptococcus pneumoniae- SENSITIVE (clearing)
Streptococcus pyogenes- RESISTANT (no clearing)
Bacitracin/Optochin sensitivity
Bacitracin- Strep pyogenes Sensitive
Strep pneumoniae Resistant
Optochin- Strep pneumoniae Sensitive
Strep pyogenes- Resistant
Bile Esculin
Selective/Differential Agar
Bile- Selective agent
Esculin- Differential agent (turns BLACK if positive)
Positive- Strep bovis
Enterococcus faecalis
Negative- Strep pyogenes

Bile Esculin test
Positive- Strep bovis
Enterococcus faecalis
Negative- Strep pyogenes
6.5% Salt broth
Selective Agar- salt is the selective agent
Turbidity- Positive
Clear- Negative
Positive- Staph, Bacillus, Enterococcus faecalis
Negative- Strep pyogenes

6.5% Salt broth
Positive- Staph, Bacillus, Enterococcus
Negative- Strep
Oxidase test
Tests for cytochrome oxidase of aerobic pathway.
Apply bacterium to swab, add oxidase reagent.
Blue/Black on swab is positive.
Positive- Pseudomonas
Neisseria sicca

Oxidase test
Positive- Pseudomonas, Neisseria sicca


